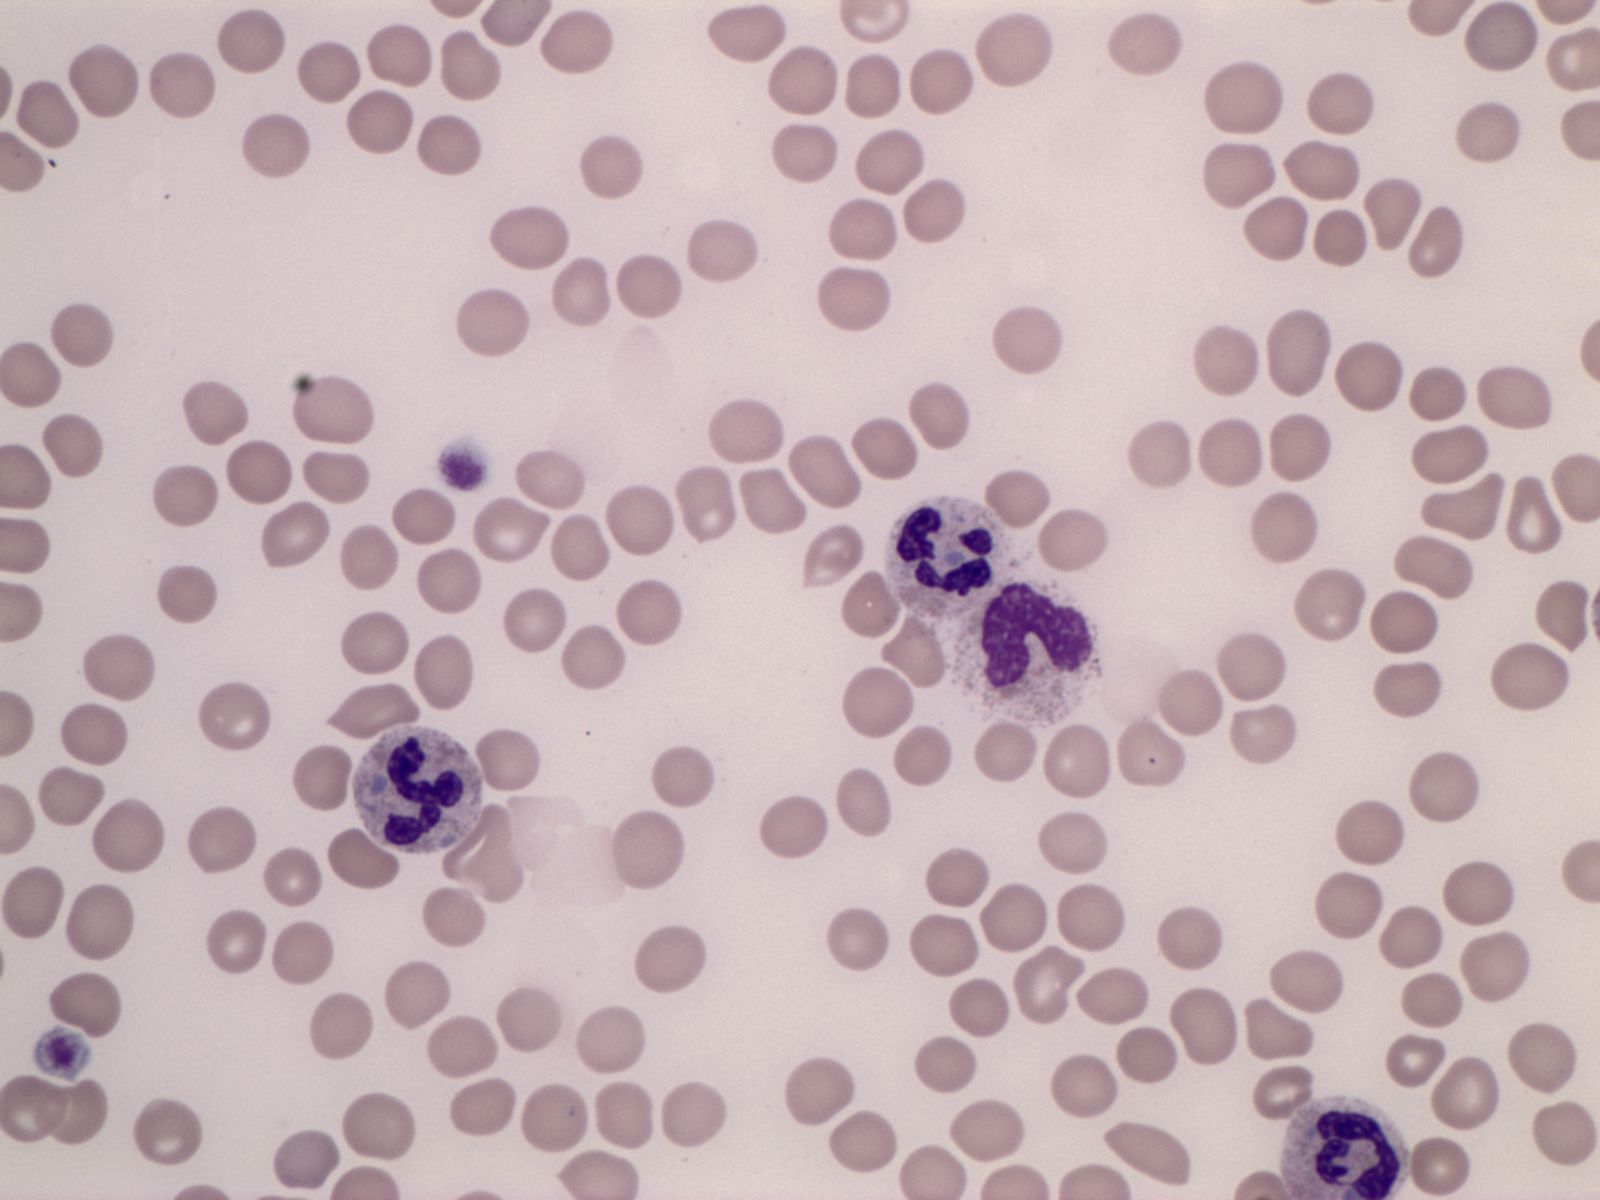

✨ Platform Features
Experience PathDojo in Action
See how it works. Try some PathDojo questions and explore the features that make our platform the best choice for pathology exam preparation.
See how it works. Try some PathDojo questions.
Sample Question
Clinical Pathology
A peripheral blood smear shows light blue inclusions in the cytoplasm of neutrophils, and large platelets. Which of the following is the most likely diagnosis?
Summary: May-Hegglin anomaly: thrombocytopenia, giant platelets with few granules, and light blue inclusions peripherally located in the cytoplasm of granulocytes. AD.
💡 This is a demo question. Sign up to access 1700+ questions
What's Included in Every Plan
High-quality questions, extensive feedback, and modern technology make PathDojo one of the best online pathology review resources in the world. Each PathDojo plan includes the following features: